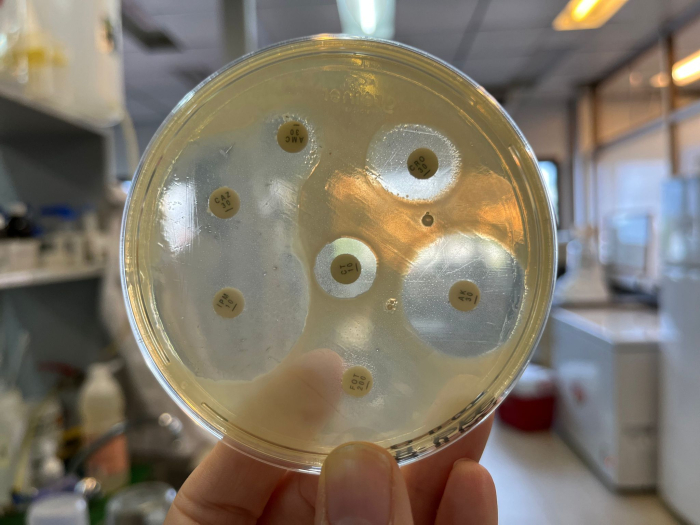
Sensibilidad antibiótica de Escherichia coli aislada de fecas de Guazubirá (Mazama gouazoubira) Sensibilidad antibiótica de Escherichia coli aislada de fecas de Guazubirá (Mazama gouazoubira)

Bioexploradores nocturnos
Exploración nocturna para niñas y niños, en búsqueda de artrópodos.
Exploración nocturna para niñas y niños, en búsqueda de artrópodos.
Invitamos al próximo encuentro del Seminario IIBCE el viernes 21 de noviembre a las 12:00 en modalidad híbrida, en el Salón de Actos del Instituto (Avenida Italia 3318) y vía Zoom.
Invitamos al evento de fin del proyecto ANII FMV Usina de Códigos de Barra de la Vida, coordinado por Mariana Cosse del IIBCE junto a Mauricio Bonifacino de Udelar como corresponsable.
Cada año, entre el 18 y el 24 de noviembre, se celebra la Semana Mundial de Concientización sobre el Uso de los Antimicrobianos.

Exploración nocturna para niñas y niños, en búsqueda de artrópodos.

Invitamos al evento de fin del proyecto Usina de Códigos de Barra de la Vida, coordinado por Mariana Cosse del IIBCE junto a Mauricio Bonifacino de Udelar como corresponsable, proyecto ANII Fondo...

En una cuenca subtropical de Uruguay, un nuevo estudio analiza cómo la intensificación agrícola influye en la abundancia y composición de los insectos polinizadores.

Un equipo del Instituto de Investigaciones Biológicas Clemente Estable (IIBCE) y la Facultad de Ciencias (Universidad de la República) realizó el primer estudio en Uruguay que utiliza ADN...

Invitamos al segundo evento científico y artístico de Ciencia al toque: construyendo futuro juntas, el lunes 24 de noviembre de 19:30 a 21:30 en el Museo Nacional de Historia Natural, Miguelete...